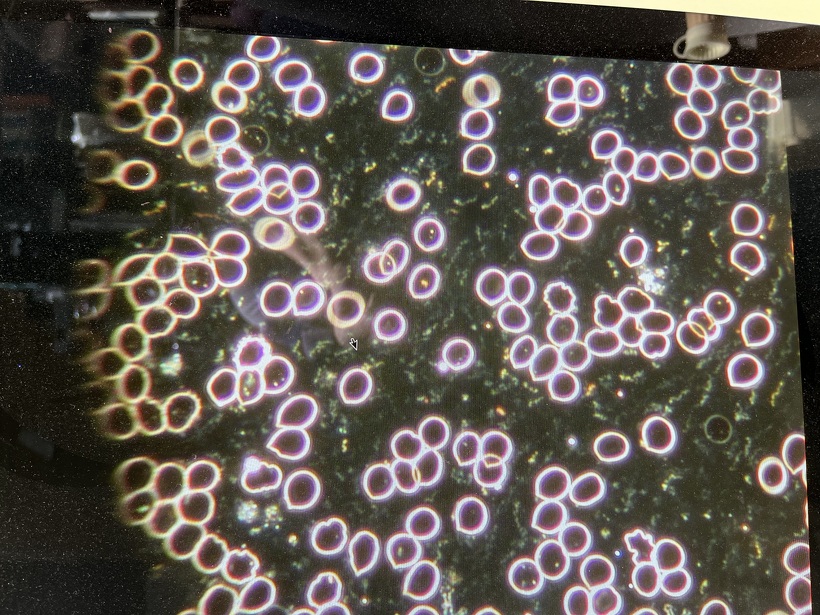

歯周病・糖尿病・癌の再発を抱えながら自宅で元気に旅立たれた方の症例
治療の結果上下で10本が残りました。上顎は2本の歯を総義歯の中に組み込みました。下顎のコーヌスブリッジ義歯 8本の支台歯(実際は7本ですが右下6番は根を2つに分割して使用しています)で14本の歯を作りました。
写真2は血液中の赤血球像です。見事にドロドロです。食事指導の結果写真6のようにバラバラになりました。
80歳から96歳まで16年間拝見しました。16年間で失った歯は亡くなる直前に0.5本でした。歯周病・糖尿病・癌の状態もよく最後は自宅で亡くなりました。歯周病と糖尿病と癌はお友達疾患であり、歯周病の状態が改善すれば悪い友達も寄り付かなくなります。
治療は自家用車で通院していただいていましたが、96歳のある日「歯が調子が悪い。自宅に往診頼む」と連絡がありました。往診の準備をしていると亡くなりましたと連絡が入りました。自宅で最期を迎えられました。